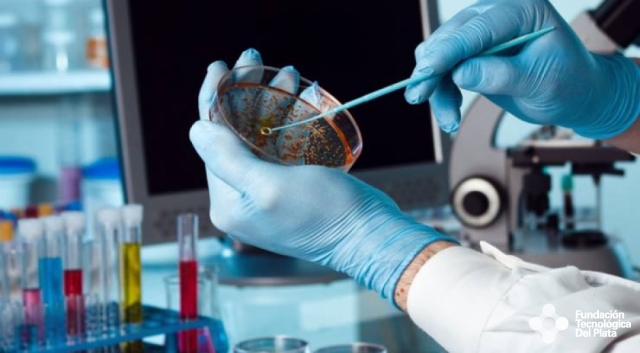
El reto de remdesivir: decidir qué pacientes y países lo recibirán primero. Imagen Miniatura

El reto de remdesivir: decidir qué pacientes y países lo recibirán primero
La mañana el 29 de abril empezaron a correr las buenas noticias. Primero a través de un vago comunicado de prensa de la compañía y luego, a mediodía, desde la Casa Blanca de EE. UU. Parece que el medicamento llamado remdesivir realmente funciona contra el coronavirus que provoca la COVID-19.
La noticia fue comunicada al presidente del país, Donald Trump, por el director del Instituto Nacional de Alergias y Enfermedades Infecciosas (NIAID) de EE. UU., Anthony Fauci, quien afirmó que los pacientes de COVID-19 que han recibido este medicamento antiviral se recuperaron 31 % más rápido, en 11 días en vez de en 15, según un ensayo controlado con placebo realizado por su agencia. "Aunque no parezca un golpe definitivo al 100 %, es una prueba de concepto muy importante. Demuestra que un medicamento puede bloquear este virus", explicó Fauci ante Trump.
El hallazgo de que remdesivir ayuda a los pacientes de COVID-19 supone un paso adelante para sacarnos de los desastres sanitarios y económicos causados por la pandemia, y aumenta la esperanza de que aparezcan otros medicamentos. Más adelante, en verano, podrían llegar los nuevos medicamentos de anticuerpos para combatir la enfermedad, y en los meses posteriores llegarían las vacunas.
El antiguo director de la Administración de Medicamentos y Alimentos de EE. UU. (FDA, por sus siglas en inglés) Scott Gottlieb, le dijo a la CNBC que, además de formar parte de un posible y "sólido conjunto de herramientas" (entre las que se incluye la mejora en la realización de pruebas), remdesivir "podría mitigar el riesgo y el temor de que esto sea una carrera hacia el abismo sin que tengamos nada para ayudarnos a salir de él". El experto añadió: "Creo que gracias a todo esto, la situación en otoño será muy diferente y podremos volver a tener una especie de normalidad en nuestras vidas, incluso con la COVID circulando de forma latente".
Remdesivir es un producto de la compañía de biotecnología con sede en California (EE. UU.) Gilead Sciences, entre cuyos éxitos destaca la producción de una cura a escala masiva contra la hepatitis C.
Los datos clínicos del ensayo aún no se han publicado, y un estudio previo en China no encontró ningún beneficio en los casos graves. Pero si se aceptan estos nuevos hallazgos, remdesivir no tardará en convertirse en el principal tratamiento contra la COVID-19.
Este fin de semana la FDA aprobó su uso de forma urgente y se espera que Gilead haga un gran esfuerzo para producir suficiente cantidad de este medicamento.
Fauci, en sus comentarios, comparó este resultado inicial con el lanzamiento de AZT, uno de los primeros medicamentos que demostró un éxito moderado en el tratamiento del VIH, el virus que causa el SIDA. Y recordó que después de AZT empezaron a aparecer otros medicamentos cada vez más efectivos.
Además de acortar los tiempos de recuperación, también existen indicios de que remdesivir redujo la posibilidad de muerte por COVID-19, pero estos datos no parecen tan sólidos. La tasa de letalidad de los pacientes que recibieron este medicamento fue del 8 %, frente al 11,6 % de los que no lo recibieron. De todas formas, las cifras son un recordatorio de la gran posibilidad de muerte de una persona ingresada por problemas respiratorios causados por COVID-19.
El estudio del NIAID comenzó el 21 de febrero. La mitad de los pacientes recibieron remdesivir de Gilead y a la otra mitad se le administró un medicamento placebo. El primer paciente del ensayo fue un estadounidense que contrajo el virus en el crucero Diamond Princess y que recibió el tratamiento en la Universidad de Nebraska (EE. UU.). En total, alrededor de 1.000 enfermos se unieron al estudio, en diferentes sitios de EE. UU., Alemania, España, Grecia y Reino Unido, entre otros.
Remdesivir pudo convertirse en fármaco para los ensayos contra COVID-19 tan rápido porque se trata de un medicamento reutilizado, lo que significa que ya se había estudiado para otros usos. Los anteriores experimentos de laboratorio habían mostrado que podía bloquear el virus del SARS en laboratorio, y también se probó en pacientes con ébola. El medicamento inhibe una molécula que los virus de ARN necesitan para crear nuevas copias de sí mismos.
El 4 de abril, el CEO de Gilead, Daniel O'Day, afirmó que la compañía tenía suficiente medicamento disponible o casi terminado para tratar a 140.000 personas y que esas dosis se utilizaban en ensayos clínicos o se ofrecían a los pacientes "sin coste alguno".
Ahora surgen enormes dudas sobre cómo distribuir las dosis de manera justa y cuánto podría costar el medicamento. Parece inevitable que surja un fuerte debate sobre qué pacientes y países deberían tener acceso prioritario a los suministros limitados del medicamento.
La fabricación de remdesivir ocurre en etapas (los componentes químicos se añaden en pasos sintéticos) y se tardan varios meses en fabricar un lote. Gilead asegura que ha incrementado la producción y que podría generar suficiente cantidad para tratar a un millón de personas hasta el final de este año. No obstante, los casos confirmados ya multiplican esa cifra por más de tres, y la cifra oficial de muertos se acercaba a los 250.000 el pasado 4 de mayo.
Se necesitan más estudios para determinar la dosis óptima y los tipos de pacientes que más se benefician. Un grupo de investigadores expresó en un libro blanco publicado recientemente que el Gobierno de EE. UU. debería permitir que más empresas fabriquen remdesivir y tomar medidas para reutilizar las líneas de producción química para producirlo en grandes cantidades.
Ese grupo, en el que figura el químico de la Universidad de Harvard (EE. UU.) Stuart Schreiber, cree que remdesivir debería administrarse poco después del inicio de los síntomas y en dosis más altas. Los expertos escribieron: "Suponemos que la dosis actual se decidió debido a los suministros limitados. Instamos al Gobierno a determinar los hechos en torno a este asunto para que se puedan establecer las dosis óptimas para los estudios de eficacia".
Gilead, por otro lado, publicó los resultados de un estudio en el que los períodos de administración de remdesivir de cinco y diez días parecían tener efectos similares. Administrarlo durante menos tiempo podría ser una forma de racionar los suministros
Fuente: MIT TECHNOLOGY REVIEW
